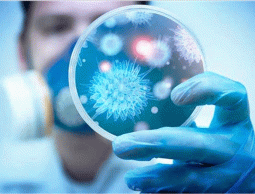

سجلت وزارة الصحة الإسرائيلية، 714 إصابة بفيروس كورونا المستجد خلال يوم واحد فقط،
ووفقا للمعطيات الصادرة عن "مركز المعلومات والمعرفة الوطني للحرب على كورونا"، بلغت حصيلة الإصابات النشطة في البلاد 7015 إصابة، فيما أظهرت نتائج 18 ألفا من فحوصات اكتشاف كورونا أن 4% من النتائج موجبة.
وأوضحت وزارة الصحة أن عدد الإصابات التي شخصت خلال الـ24 ساعة الأخيرة، تعتبر أعلى حصيلة إصابات شخصت منذ الثاني من نيسان/أبريل الماضي، وهو ثالث يوم يسجل به أعلى معدل إصابات بالفيروس في البلاد.
وبحسب الإحصائيات فإن الإصابات النشطة البالغ حصيلتها 7015 إصابة تعتبر الأعلى منذ شهر أيار/مايو الماضي، حيث توقفت الحصيلة عند الـ5000 إصابة، إذ سجلت أكثر من 2000 إصابة خلال شهر واحد فقط.